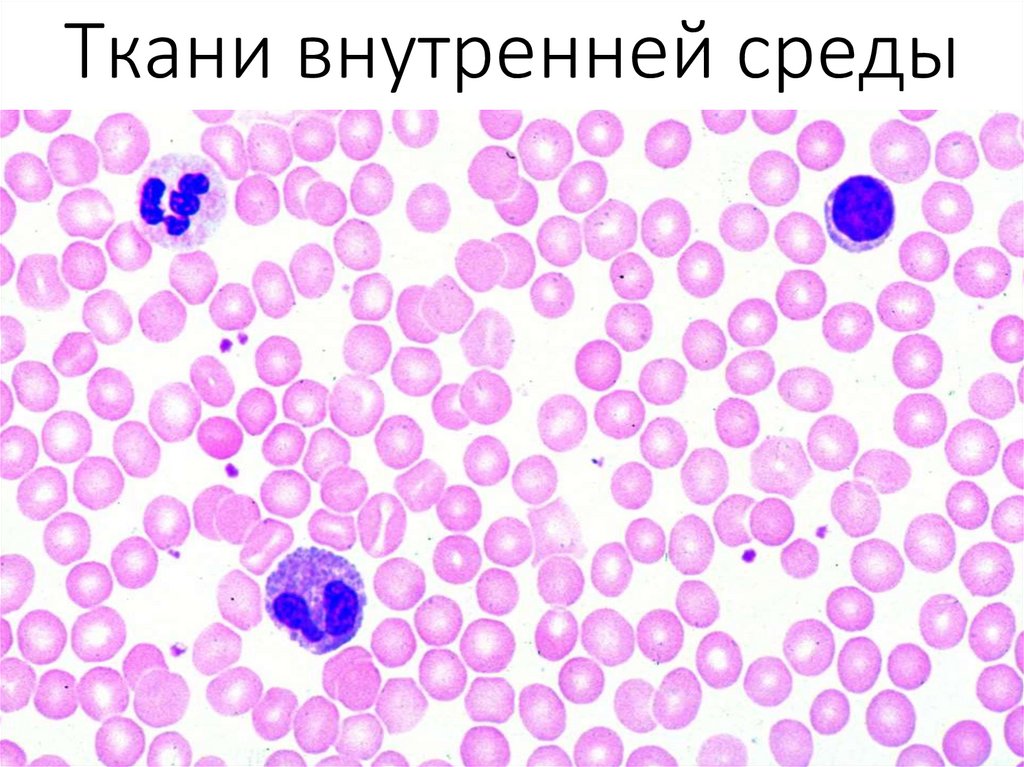

Похожие презентации:
Ткани внутренней среды
1. Ткани внутренней среды
2. Ткани внутренней среды
1. располагаются внутри организма, не контактируя свнешней средой и полостями внутренних органов;
2. содержат много межклеточного вещества;
3. клетки не обладают полярностью;
4. развиваются из мезодермы и ее производных;
5. способны к физиологической и репаративной
регенерации, обладая собственными стволовыми
клетками;
6. создают и поддерживают внутреннюю среду
организма.
3.
4.
5. Кровь
Кровь — жидкая и подвижная соединительная ткань внутренней средыорганизма. Состоит из жидкой среды — плазмы — и взвешенных в ней
форменных элементов (эритроцитов, лейкоцитов и тромбоцитов).
Циркулирует по замкнутой системе сосудов под действием сокращающегося
сердца и не сообщается непосредственно с другими тканями тела ввиду
наличия гистогематических барьеров.
6. Функции крови
Транспортная:кислород от лёгких к тканям и углекислый газ — от тканей к лёгким;
питательные вещества ко всем клеткам;
продукты обмена веществ:
NH3 — от всех клеток к печени, почкам и коже;
мочевину — от печени к почкам;
сигнальные молукулы.
Терморегуляторная:
поддерживает температуру тела благодаря содержанию большого количества
воды (высокотеплоёмкого вещества).
Защитная:
обеспечение иммунной защиты от антигенов за счет наличия в крови
иммунокомпетентных клеток (макрофаги, лимфоциты и др.).
Гомеостатическая:
поддержание гомеостаза (постоянства внутренней среды организма) — кислотноосновного равновесия, водно-электролитного баланса и т. д.
Опорно-амортизирующая:
придание дополнительной упругости органам за счёт наличия в их сосудах крови
под давлением.
7. Кровь
Плазма крови — жидкая часть крови, лишенная форменных элементов.Процентное содержание плазмы в крови составляет 52—61 %.
Гистологически плазма является межклеточным веществом жидкой ткани
крови.
8. Кровь
9. Кровь
10. Кровь
11. Эритроциты
12. Эритроциты
13. Эритроциты
Гемоглобин14. Эритроциты
Система поверхностных антигенов АВ015. Тромбоциты
Мегакариоцит16. Тромбоциты
17. Лейкоциты
ЛейкоцитыГранулоциты
• Базофилы
• Нейтрофилы
• Эозинофилы
Агранулоциты
• Моноциты
• Лимфоциты
18. Гранулоциты
Нейтрофилы. Являютсяосновными
фагоцитами кровотока, но в ходе
острого воспаления интенсивно
мигрируют в очаг воспаления
Эозинофилы. Борьба с
многоклеточными паразитами за
счёт неклеточного цитолиза их
клеток.
Базофилы.
Разновидность лейкоцитов,
которые участвуют в развитии
аллергических реакций.
19. Нейтрофил
20. Нейтрофил
21. Эозинофил
22. Базофил
23. Агранулоциты
Лимфоциты. Главное звеногуморального и клеточного
приобретённого специфического
иммунитета.
Моноциты.
Являются клетками врождённого
иммунитета, могут перемещаться
в очаг воспаления, где
секретируют провоспалительные
цитокины и участвуют
в фагоцитозе.
24. Лимфоцит
25. Моноцит
26. Гемопоэз
27. Гемопоэз
НормобластРетикулоцит
28. Гемопоэз
Костный мозг29. Лимфатическая система
Пути транспорталимфы:
лимфатические
капилляры
лимфатические
сосуды
лимфатические
стволы и протоки
Лимфоидные
органы:
Центральные органы
иммунной
системы:
• тимус (вилочковая
железа)
• красный костный мозг
Периферические органы и
системы:
• лимфатические узлы
• печень
• селезёнка
• миндалины
• лимфатические
фолликулы
• пейеровы бляшки
30. Лимфатическая система
31. Лимфатическая система
Тимус32. Лимфатическая система
Лимфатический узел33. Лимфатическая система
Ретикулярная клеткаДендроцит
34. Лимфатическая система
Типы лимфоцитовТ-лимфоциты
Т-хелперы (CD4+)
Т-киллеры
(цитотоксические
CD8+)
B-лимфоциты
T-супрессоры
NK-лимфоциты
Гамма/дельта Тлимфоциты

Медицина
Медицина








